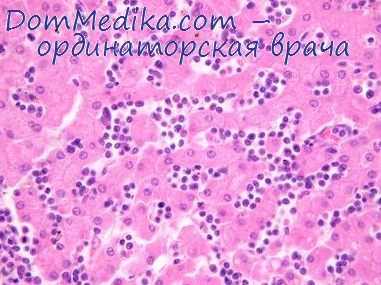
гемопоэтические факторы роста

Гемопоэтические факторы роста (гемоцитокины) - функции, участие в гемопоэзе
Добавил пользователь Валентин П. Обновлено: 11.12.2025
Онкология:
Популярные разделы сайта:
Гемопоэтические факторы роста. Гемоцитокины
В нормальных условиях срок жизни клеток крови человека варьирует от нескольких лет (лимфоциты) до нескольких часов (нейтрофилы), поэтому организм постоянно нуждается в их количественном восполнении. Дополнительные стрессорные факторы, как, например, гемолиз или инфекция, требуют повышенной продукции потребляющихся клеток, соответственно эритроцитов или нейтрофилов. Лимфоцитам и моноцитам для эффективною осуществления иммунной реакции, помимо количественного восполнения, необходима также качественная перестройка. Существующая специализированная регуляторная система кроветворения позволяет обеспечивать эти постоянно изменяющиеся потребности организма.
Источником различных клеток крови является родоначальная стволовая кроветворная клетка. Механизмы регуляции гемопоэза реализуются при взаимодействии стволовых клеток друг с другом, с клетками микроокружения (фибробластами, макрофагами, эндотелиальными и стромальными клетками) и с окружающей кровью. Эти контакты влияют на миграцию, адгезию, пролиферацию и дифференцировку стволовых клеток, что позволяет осуществлять постоянную замену разрушающимся' клеточным элементам крови, а также оперативно изменять продукцию определенных клеток в ответ на стрессорные ситуации. Одним из наиболее важных начал регуляции кроветворения является воздействие гемопоэтических факторов роста идя гемоцитокинов на стволовые клетки. Эти вещества имеют полипептидную природу и содержатся в плазме или передаются при непосредственном контакте клеток друг с другом.
Вначале об эффекте гемоцитокинов судили по их способности стимулировать пролиферацию кроветворных клеток костного мозга с образованием колоний в полужидкой питательной среде. Рост колоний клеток был возможен только при добавлении в среду с клетками костного мозга экстракта плаценты или наличия «подложки» из других клеток, например фибробластов, выделяющих необходимые для роста колоний вещества. Некоторые из этих веществ вызывают быстрый рост колоний клеток крови определенного ростка или нескольких ростков. В 1970-х годах они были охарактеризованы как полипептиды и получили название колониестимулирующих факторов - КСФ, или гемоцитокинов.
Процесс созревания стволовой клетки до специализированной (эритроцита, лейкоцита и г.д.) включает несколько этапов. На каждом из них меняется состав рецепторов к различным гемоцитокинам на мембранах кроветворных клеток. На наиболее ранних предшественниках гемопоэза имеются рецепторы к цитокинам, вызывающим рост малодифференцированных клеток, - фактору стволовых клеток и STK-1. После периода созревания на них появляются рецепторы к ИЛ-3, вызывающему рост мультилииейных колоний. Отдельные клетки мультилииейных колоний в дальнейшем дают рост однолинейных колони, экспрессирующих рецепторы к поздним линейным цитокинам. Последние клетки дают наиболее выраженный пролиферативный ответ при добавлении поздних цитокинов Г-КСФ. М-КСФ, эритропоэтина и тромбопоэтина.
Таким образом, за счет изменения состава рецепторов ранние цнтокнпы делают клетку чувствительной к другим цитокинам. вызывающим ее созревание в определенном направлении. Это позволяет увеличивать продукцию необходимых в данный момент клеток крови при взаимодействии стволовых клеток с комбинациями различных цитокинов. Следует отметить, что некоторые из цитокинов могут вызывать одновременно и активацию ранних клеток-предшественников гемопоэза и пролиферацию поздних предшественников определенной линии крови Например, рецепторы к такому позднему гемостимулятору, как Г-КСФ, имеются и на наиболее ранних стволовых клетках, а фактор стволовых клеток вызывает пролиферацию, созревание и активацию тучных клеток. Рег уляторное воздействие цитокинов на кроветворение определяется как самим наличием на клетке тех или иных рецепторов к ним, так и действием различных комбинаций гемоцитокинов.
Например, сочетание ИЛ-3, активирующем» ранние предшественники гемопоэза, с Г-КСФ, действующим на относительно зрелые клетки-предшественники, приводит к более выраженной стимуляции гранулоцитопоэза, чем их воздействие по отдельности.
Многие цитокины способны вызывать продукцию других цитокинов, что обусловливает опосредованную регуляцию гемопоэза. Например, ИЛ-1 вызывает продукцию Г-КСФ, ГМ-КСФ ИЛ-6 стромальными клетками, а ИЛ-3 приводит к экспрессии гена М-КСФ в моноцитах. Подобная взаимосвязь регуляторных механизмов иммунологической и гемопоэтической системы позволила некоторым авторам предложить термин «цитокиновая сеть».
ГЛАВА 6 ГЕМОПОЭТИЧЕСКИЕ ФАКТОРЫ РОСТА: БИОЛОГИЧЕСКИЕ ОСНОВЫ ФУНКЦИОНИРОВАНИЯ И КЛИНИЧЕСКОЕ ПРИМЕНЕНИЕ
нормальных условно срок жизнн клеток крови человека варьирует от нескольких лет (лимфоциты) до нескольких часов (нейтрофилы), поэтому организм постоянно нуждается я их количественном восполнении.
Дополнительные стрессор- ные факторы, как, например, гемолиз или инфекция, 'гребуют повышенной продукции потребляющихся клеток, соответственно эритроцитов или нейтрофилов. Лимфоцитам и моноцитам для эф- фектнвного осуществления иммунной реакции, помимо количественного восполнения, необходима также качественная перестройка. Существующая специализированная регуляторная система кроветворения позволяет обеспечивать эти постоянно изменяющиеся потребности организма.
Источником различных клеток крови является родоначальная стволовая кроветворная клетка. Механизмы регуляции гемопоэза реализуются при взаимодействии стволовых клеток друг с другом, с клетками микроокружения (фибробластами, макрофагами, эндотелиальными и стромальными клеткам») и с окружающей кровью. Эти контакты влияют на миграцию, адгезию, пролиферацию и дифференцнровку стволовых клеток [9], что позволяет осуществлять постоянную замену разрушающимся клеточным элементам крови, а также оперативно изменять продукцию определенных клеток в ответ на стрессорные ситуации. Одним из наиболее важных начал регуляции кроветворения является воздействие гемопоэтических факторов роста или гемоцитокннов на стволовые клетки. Эти вещества имеют полипептндную природу и содержатся в плазме или передаются при непосредственном контакте клеток друг с другом.
Вначале об эффекте гемоцитокннов судили по их способности стимулировать пролиферацию кроветворных клеток костного мозга с образованием колоний в полужидкой питательной среде. Рост колоний клеток был возможен только при добавлении в среду с клетками костного мозга экстракта плаценты или наличия «подложки» из других клеток, например фибробластов, выделяющих необходимые для роста колоний вещества
Некоторые из этих веществ вызывают быстрый рост колоний клеток крови определенно ростка или нескольких ростков. В 1970-х год они были охарактеризованы как полипептиды получили название колониестимулирующих фак торов — КСФ (С5Р), или гемоцитокннов [132].
Источником значительной части гемоцнток нов являются клетки стромы костного мозга Этот факт подтверждается возможностью суше ствования долговременной (месяцы) культур стволовых кроветворных клеток при их со имеет ном культивировании с клетками стромы без д бавления цитокинов извне [52]. Нарушение непос редствениого контакта между стромальными и г' мо поэтическим и клетками приводит к остановк процессов кроветворения [52, 102]. Помимо стр мы, гемоцитокины продуцируются многими типа ми клеток, не имеющих прямого отношения ■ костному мозгу (фибробласты, эндотелий, кортг калъные клетки почек и др.). Эта продукция м нястся при воздействии различных стимулов, чт может влиять на регуляцию кроветворения. В частности, эндотелиальные клетки значитеяьн усиливают синтез гранулоцн'тарного колониести- мулнрующего фактора (Г-КСФ) при воздействи бактериального эндотоксина [37]. а клетки поче увеличивают образование эритропоэтика в отв на гипоксию [126].
Гемоцитокины оказывают разноплановое би логическое действие на клетки-мишени. Некот рые из них помимо воздействия на процессы г моиоэза способны также влиять на функции уж зрелых клеток крови. Гранулоцптарнын (Г-КСФ или С-СЙР) и гранулоцнтарно-макрофагалькь колониестнмулнрующнй (ГМ-КСФ, или ОМ-С& факторы способны активировать антибактериаЛ' ные функции нейтрофилов [5, 211]. Г-КСФ, кр ме того, ускоряет миграцию нейтрофилов из деп костного мозга в периферическую кровь
С.8Р) усиливает цитотоксическне свойства мон цитов, а также участвует в процессах метаболи ма костной ткани [105].
В настоящее время известно около 30 биологически активных веществ, влияющих на процессы гемопоэза. Несмотря на то что многие из ге- моцитокннов обладают сходным биологическим эффектом, среди них не было отмечено значительной гомологии в первичной структуре (аминокислотной последовательности) за исключением громбопоэтина и эритропоэтина [193].
При структурном анализе молекул гемопоэтических факторов роста было выявлено сходство в конфигурации некоторых из них (Г-КСФ, ГМ-КСФ, ИЛ-2, ИЛ-4, ^-интерферон), заключающееся в характерном чередовании спиральных участков полипеп- гидной цени [85]. Подобная структурная гомология может свидетельствовать о сходном характере связывания со специфическими рецепторами. Большинство из цитокинов синтезируется вместе с гидрофильным пептидом — проводником, который впоследствии отщепляется от активной молекулы. Карбогидратный (гликозидный) компонент зависит часто от тканевого источника цитокина *( может определять стабильность молекулы.
Каждый цитокин или фактор роста кодируется своим собственным геном. В настоящее время охарактеризованы многие из генов, кодирующих синтез колоннестимулнрующих факторов. Известно. что на длинном плече 5 хромосомы человека содержится целый кластер таких генов, включавший гены Г-КСФ и ГМ-КСФ, интерлейкина 3 И Л-3). Кроме того, эта область хромосомы содержит гены рецепторов к колониестимулирую- ним факторам, в частности к М-КСФ. ИЛ-4 и ИЛ-5 [104].
Эффект гемоцитокинов реализуется при их взаимодействии со специфическими мембранными рецепторами клеток — предшественников кроветворения. Молекулы внеклеточного (наружного) ьэм по цента многих цитокиновых рецепторов имеет сходные по аминокислотной последовательности области (\У5Х\У8 участок) [41]. Последний аакт заставил исследователей отнести эти цмто- «нновые рецепторы (эритропоэтина, Г-КСФ. ГМ- КСФ. многих интерлейкинов, интерферона у и -ф.| к отдельному суперсемейству. К этому супер- ггменству не относятся рецепторы к фактору гтводовых клеток и макрофагального колоннести- «^лнрующего фактора Репе!торы к цитокинам «еются и на некоторых клетках, не относящих-
з к системе крови. В частности, на эндотелналь- клетках есть рецепторы к Г-КСФ и ГМ- 5СФ. и в культуре оба цитокина вызывают про- жферацию и миграцию эндотелия [34]. Эти ре- агпторы представлены также на некоторых опу- юлевых клетках, например на клетках мелкокле- ж'шого рака легкого [173]. Рецепторы к М-КСФ ■«еются на синтициальиых клетках плаценты, остеобластах и клетках нервной системы [601.
Соединение большинства гемоцитокинов с рецептором приводит к образованию промежуточных активаторов (МАР-кинаэы). В частности, это система ,1ак-8ТАТ-киназ [20, 212, 213], которые являются вторичными передатчиками сигнала от цитокннового рецептора к ядру клетки. В клеточном ядре эти вторичные передатчики активируют транскрипцию зффекторных генов раннего ответа [109]. Большинство из этих генов отвечает за синтез белков, способных сами по себе или в ассоциации с продуктами других генов взаимодействовать с ДНК. Данные белки являются регуляторами активности различных генов. Некоторые из них кодируют другие факторы роста, например ген .!Е или ген, стимулирующий рост меланомы (цто) [165], Таким образом, воздействие ци- токинов приводит к очень серьезной перестройке функционирования генетическою аппарата клетки.
Процесс созревания стволовой клетки до специализированной (эритроцита, лейкоцита и т.д.) включает несколько этапов. На каждом из них меняется состав рецепторов к различным гемоци- токинам на мембранах кроветворных клеток. На наиболее ранних предшественниках гемопоэза имеются рецепторы к цитокинам, вызывающим рост малодифференцированных клеток. — фактору стволовых (слеток и 5ТК-1. После периода созревания на них появляются рецепторы к ИЛ-3, вызывающему рост мультилниеиных колоний. Отдельные клетки мультилинейных колоний в дальнейшем дают рост однолинейных колоний, экспрессирующих рецепторы к поздним линейным цитокинам. Последние клетки дают наиболее выраженный пролиферативный ответ при добавлении поздних цитокинов — Г-КСФ, М-КСФ, эри гропоэтина и тромбопозтина. Таким образом, за счет изменения состава рецепторов ранние цитокины делают клетку чувствительной к другим цитокинам, вызывающим ее созревание в определенном направлении. Это позволяет увеличивать продукцию необходимых в данный момент клеток крови при взаимодействии стволовых клеток с комбинациями различных цитокинов. Следует отметить, что некоторые из цитокинов могут вызывать одновременно и активацию ранних клеток-предшеств ей ников гемопоэза и пролиферацию поздних предшественников определенной линии крови.
Например, рецепторы к такому позднему гемостимулятору, как Г-КСФ, имеются и на наиболее ранних стволовых клетках [91], а фактор стволовых клеток вызывает пролиферацию, созревание и активацию тучных клеток [63], Регуляторное воздействие цитокинов на кроветворение определяется как самим наличием на клетке тех или иных рецепторов к ним, так и действием различных комбинаций гемоцитокинов. Например, сочетание ИЛ-3, активирующего ранние предшественники гемопоэза, с Г-КСФ, действую
щим на относительно зрелые клетки-предшествен- ники, приводит к более выраженной стимуляции гранулоцитопозз а, чем их воздействие по отдельности [!51].
Многие цитокины способны вызывать продукцию других цитокинов, что обусловливает опосредованную регуляцию гемопоэза. Например, ИЛ-1 вызывает продукцию Г-КСФ, ГМ-КСФ ИЛ~6 стромальными клетками [185], а ИЛ-3 приводит к экспрессии гена М-КСФ в моноцитах [206]. Подобная взаимосвязь регуляторных механизмов иммунологической и гемопоэтической системы позволила некоторым авторам предложить термин «ци ток» нова я сеть» [9].
Синергидное и опосредованное воздействие факторов, участвующих в регуляции гемопоэза. выражается в том, что:
Регуляция гемопоэза
Кроветворение регулируется факторами роста, обеспечивающими пролиферацию и дифференцировку СКК и последующих стадий их развития, факторами транскрипции, влияющими на экспрессию генов, определяющих направление дифференцировки гемопоэтических клеток, а также витаминами, гормонами.
Факторы роста включают колониестимулирующие факторы (КСФ), интерлейкины и ингибирующие факторы. Они являются гликопротеинами с молекулярной массой около 20 КД. Гликопротеины действуют и как циркулирующие гормоны, и как местные медиаторы, регулирующие гемопоэз и диффереицировку специфических типов клеток. Они почти все действуют
'Аблица 2. Гемопоэтические факторы роста (стимуляторы)
На какие клетки-мишени действует
Интерлейкин-1 Интерлейкин-2 Интерлейкин-3
Мультипотен-циальный КСФ (мульти-КСФ)
КСФ грануло-цитов и макрофагов (ГМ-КСФ) КСФ гранулю-митоб (Г-КСФ)
КСФ макрофагов (М-КСФ)
Моноциты-макрофаги Т-лимфоциты Клетки стромы костного мозга, Т-пимфоцить. клетки эпидермиса
Клетки стромы костного мозга
Моноциты, Т-лимоциты, фибробласты, эндотелио-циты
Макрофаги, фибробласты, эндотелиоциты
Почки (интерстициальные клетки), печень
Т-лимфоциты, Б -лимфоциты СКК, КОЕ-ГЭММ, клетки-предшественники всех классов (КОЕ-Э, КОЕ-Г 1 , КОЕ-М, КОЕ-МГЦ), дифференцирующиеся клетки
В-лимфоциты, Т-лимфоциты, тучные клетки
Эозинофилы, В-лимфоциты Полипотентные клетки КОЕ-ГЭММ, КОЕ-ГМ, В-лимфоциты, Т-лимфоциты, грану-лоциты
СКК, полипотентные клетки (КОЕ-ГЭМ! КОЕ-Л, КОЕ-ГМ), гранулоциты, моноциты-макрофаги, Эозинофилы, тучньи клетки
Полипотентные клетки, гранулоциты, моноциты-макрофаги, эозинофилы, мегака-риоциты
Клетка-предшественник нейтрофилов и базофилов (КОЕ-Г). унипотентные предшественники — КОЕ-Гн и КОЕ-Б
Олигопотентная клетка КОЕ-ГМ, унипо-тентный предшественник моноцитов (КОЕ-М), гранулоциты, моноциты-макрофаги
КОЕ-МГЦ, мегакариоциты, тромбоциты
Нейтрофилы, эозинофилы, базофилы.
на СКК, КОЕ, коммитированные и зрелые клетки. Однако отмечаются индивидуальные особенности действия этих факторов на клетки-мишени.
КСФ действуют на специфические клетки или группы клеток на различных стадиях дифференцировки. Например, фактор роста стволовых клеток влияет на пролиферацию и миграцию СКК в эмбриогенезе. В постнаталь-ном периоде на гемопоэз оказывают влияние несколько КСФ, среди которых наиболее изучены факторы, стимулирующие развитие гранулоцитов и макрофагов (ГМ-КСФ, Г-КСФ, М-КСФ), а также интерлейкины.
Как видно из табл. 2, мульти-КСФ и интерлейкин-3 действуют на поли-потентную стволовую клетку, большинство КОЕ и даже на терминально дифференцирующиеся клетки. Некоторые КСФ могут действовать на одну
или более стадий гемогтоэза, стимулируя деление, дифференцировку клеток или их функцию. Большинство указанных факторов выделено и применяется для лечения различных болезней. Для получения их используются биотехнологические методы.
Большая часть эритропоэтина образуется в почках (интерстициальные клетки), меньшая — в печени. Его образование регулируется содержанием в крови О2, которое зависит от количества циркулирующих в крови эритроцитов. Снижение числа эритроцитов и соответственно парциального давления кислорода (Р0г) является сигналом для увеличения продукции эритропоэтина. Эритропоэтин действует на чувствительные к нему КОЕ-Э, стимулируя их пролиферацию и дифференцировку, что в конечном итоге приводит к повышению содержания в крови эритроцитов. К факторам роста для эритроидных клеток, кроме эритропоэтина, относится фактор бурст-промоторной активности (БПА), который влияет на БОЕ-Э. БПА образуется клетками ретикулоэндо-телиальной системы. В настоящее время считают, что он является интерлейкином-3.
Тромбопоэтин синтезируется в печени, стимулирует пролиферацию КОЕ-МГЦ, их дифференцировку и образование тромбоцитов.
Ингибирующие факторы дают противоположный эффект, т. е. тормозят гемопоэз; их недостаток может быть одной из причин лейкемии, характеризующейся значительным увеличением числа лейкоцитов в крови. Выделен ингибирующий лейкемию фактор (ЛИФ), который тормозит пролиферацию и дифференцировку моноцитов-макрофагов.
Факторы транскрипции — это специальные белки, регулирующие экспрессию генов гемопоэтических клеток.
Витамины необходимы для стимуляции пролиферации и дифференцировки гемопоэтических клеток. Витамин В]2 поступает с пищей и соединяется с внутренним фактором (Касла), который синтезируется париетальными клетками желудка. Образуемый при этом комплекс в присутствии ионов Са 2+ соединяется с рецепторами эпителиоцитов подвздошной кишки и всасывается. При всасывании в эпителио-циты поступает лишь витамин В1Э, а внутренний фактор высвобождается. Витамин В12 с помощью транскобаламина II поступает с кровью в костный мозг, где влияет на гемопоэз, и в печень, где может депонироваться. Транскобаламин II вырабатывается эпителиоцитами кишечника. Нарушение процесса всасывания при различных заболеваниях может служить причиной дефицита витамина В|3 и нарушений в гемопоэзе. Фолиевая кислота участвует в синтезе пуриновых и пиримидиновых оснований.
Гемопоэтические факторы роста
Гемопоэтические факторы роста - это гликопротеины, которые регулируют пролиферацию и дифференцировку клеток-предшественниц кроветворения, а также функцию зрелых клеток крови. Основным местом их действия является кроветворное микроокружение костного мозга. Главными источниками этих факторов роста являются Т-лимфоциты, макрофаги, эндотелиальные клетки и клетки стромы, за исключением эритропоэтина, 90% которого синтезируется в почках. Основными гемопоэтическими факторы роста являются:
Действующие на стволовые и полипотентные клетки - фактор стволовой клетки.
Действующие на полипотентные клетки - ИЛ3, ИЛ4, ИЛ6, ГМ-КСФ.
Действующие на би- и унипотентные клетки - Г-КСФ, М-КСФ, ИЛ-5 (Эоз), эритропоэтин, тромбопоэтин, лимфо (ИЛ1,2,3,4,6,7,9,10, гамма-ИФ).
Действующие на клетки микроокружения (стимуляция продукции ГМ-КСФ, Г-КСФ, М-КСФ, ИЛ-6) - ИЛ1, ТНФ.
Эффект гемопоэтических факторов роста осуществляется при взаимодействии с рецепторами клеток-мишеней. Миелоидные и лимфоидные гемопоэтические факторы роста:
действуют при очень низких концентрациях
обычно продуцируются разными типами клеток
обычно действуют более чем на один росток кроветворения
могут действовать как на клетки предшественницы, так и на более зрелые клетки
синергично взаимодействуют с другими факторами роста
могут действовать на злокачественные варианты нормальных клеток
могут влиять на пролиферацию, дифференцировку, созревание, функциональную активность, ингибируют апоптоз.
Резкая стимуляция кроветворения достигается воздействием ИЛ1, ФНО на клетки микроокружения (стимуляция продукции ГМ-КСФ, Г-КСФ, М-КСФ, ИЛ-6).
Ингибиторами кроветворных клеток являются трансформирующий фактор роста бета (действует на широкий спектр кроветворных и некроветворных клеток), а также ФНО и ИЛ4 (действуют на поздних предшественников миелопоэза).
В клинике применяются в основном рекомбинантные ГМ-КСФ, Г-КСФ (постцитостатическая цитопения, трансплантация костного мозга, лечение нейтропении, апластической анемии и миелодисплазии, лечение острых лейкозов) и эритропоэтин (анемия при уремии, злокачественных опухолях).
Эритропоэз
Клетками-предшественницами эритроидного ряда, которые культивируются in vitro, являются общая клетка-предшественницами миелопоэза, а также эритроидные бурстобразующие и колониеобразующие клетки.
Наиболее ранней морфологически распознаваемой клеткой эритроидного ряда в костном мозге является пронормоцит, который представляет собой (при обычной окраске по Романовскому-Гимза) крупную клетку с темно-голубой цитоплазмой, центрально расположенным ядром с ядрышками и грубоватой структурой хроматина. В результате нескольких клеточных делений и дифференцировки образуются клетки меньших размеров - базофильные, полихроматофильные и оксифильные нормоциты. По мере развития клеток эритроидного ряда уменьшаются размеры ядра, в цитоплазме клеток снижается содержание РНК и продуцирующих белок органелл (окраска становится бледно-голубой) и накапливается гемоглобин (окраска становится розоватой). Оксифильный нормоцит теряет ядро и превращается в ретикулоцит, который сохраняет остатки рибосомальной РНК и еще способен к синтезу гемоглобина. Продолжительность эритропоэза около 12 суток.
Ретикулоциты, которые несколько крупнее эритроцитов, в течении 1-2 суток остаются в костном мозге, а затем поступают в циркулирующую кровь, где окончательно созревают в течении 1-2 суток (преимущественно в селезенке). В процессе этого созревания они полностью теряют РНК и способность к синтезу гемоглобина, после чего приобретают морфологические признаки эритроцита. Ретикулоциты в норме составляют 0,5-2% эритроцитов периферической крови. Нормоциты в норме в периферической крови не определяются , их появление может свидетельствовать о внекостномозговом кроветворении или о патологии костномозгового кроветворения.
Зрелый эритроцит представляет собой безъядерную двояковогнутую дисковидную клетку. Из одного пронормоцита обычно образуется 16 эритроцитов. Эритроциты циркулируют в кровотоке примерно 120 суток, после чего они захватываются мононуклеарными фагоцитами и разрушаются.
В регуляции пролиферации и дифференцировки клеток-предшественниц эритропоэза принимают участие многочисленные стимуляторы и ингибиторы (фактор роста стволовой клетки, ИЛ-3, ГМ-КСФ и др.), но основным регулятором эритропоэза является эритропоэтин. Молекулярный вес эритропоэтина 30 400, белковая часть его (61% массы) состоит из 165 аминокислот, 39% массы составляют углеводы. Время полураспада эритропоэтина в плазме крови - 6-9 часов. В норме около 90% эритропоэтина вырабатывается околоканальцевым комплексом почек, а 10% - печенью и другими органами и тканями. Сохраняющихся запасов эритропоэтина в организме нет, и основным регулятором его продукции является напряжение кислорода в ткани почек. Продукция эритропоэтина возрастает при снижении поступлении кислорода в ткани почек, чему может способствовать анемия, неспособность гемоглобина вследствии структурных или метаболических причин нормально отдавать кислород, снижение содержания кислорода в воздухе, а также нарушение функции сердечно-сосудистой и дыхательной систем или кровоснабжения почек.
Эритропоэтин способствует увеличению количества клеток-предшественниц эритропоэза. Он воздействует на рецепторы КОЕ-э и поздних БОЕ-э, что приводит к стимуляции пролиферации, дифференцировки и образова-ния гемоглобина. При этом содержание клеток эритроидного ряда в костном мозге возрастает, а в случаях хронического увеличения продукции эритропоэтина может развиваться замещение жирового костного мозга клеточным или внекостномозговое кроветворение.
С другой стороны, увеличение содержания кислорода в тканях (вследствии повышения количества эритроцитов или способности гемоглобина отдавать кислород) приводит к снижению продукции эритропоэтина.
Способностью стимулировать эритропоэз обладают некоторые гормоны, такие как андрогены, катехоламины, тиреодные гормоны, соматотропный гормон и др.
Нормальный костный мозг способен увеличить продукцию эритроцитов в 3-5 раз по сравнению с нормой через 1-2 недели после мощной стимуляции, а при хронических гемолитических анемиях эффективность эритропоэза может возрастать в 5-7 раз.
Кроветворное микроокружение.
Нормальное функционирование и дифференцировка СКК могут происходить только при наличии соответствующего кроветворного микроокружения, т.е. в участках костного мозга, которые имеют определенную структуру стромы и экстрацеллюлярного матрикса (таблица 2.1).
Основные компоненты кроветворного микроокружения.
Протеогликаны (хондроитин, гепарин)
Влияние кроветворного микроокружения на гемопоэз реализуется: 1)путем прямых межклеточных контактов между СКК и клетками стромы; 2)при взаимодействии ростовых факторов с молекулами экстрацеллюлярного матрикса и мембранными протеинами; 3)продукцией компонентами кроветворного микроокружения позитивных и негативных регуляторов гемопоэза.
С помощью экспрессируемых клеточной поверхностью адгезивных молекул СКК связывается со специфическими структурами (лигандами) экстрацеллюлярного матрикса и клеток стромы. Ростовые факторы, продуцируемые стромальным клетками и СКК, играют важную роль в регуляции деятельности и направления дифференцировки клеток-предшественниц.
Ростовые факторы.
Большое значение в нормальном функционировании системы гемопоэза имеют ростовые факторы, к которым относятся собственно гемопоэтические ростовые факторы и интерлейкины. Гемопоэтические ростовые факторы называются также колониестимулирующими факторами, поскольку они обладают способностью стимулировать клетки-предшественницы различных линий к образованию колоний созревающих клеток in vitro. Характеристика основных свойств ростовых факторов представлена в таблице 2.2.
Общая характеристика ростовых факторов.
1. Обладают множественной биологической активностью.
2. Индуцируют пролиферацию и дифференцировку клеток-предшественниц и
повышают функциональную активность зрелых клеток.
3. Обычно продуцируются различными видами клеток.
4. Обычно оказывают действие более чем на одну клеточную линию.
5. Обычно действуют синергично с другими ростовыми факторами.
Основная часть ростовых факторов продуцируется Т-лимфоцитами, моноцитами (макрофагами), эндотелиальными клетками и фибробластами (стромальными клетками). Исключением является эритропоэтин, 90% которого синтезируется в почках.
Важным свойством ростовых факторов является их иерархическое действие, т.е. влияние на различные по зрелости гемопоэтические клетки (таблица 2.3).
Иерархическое действие ростовых факторов.
Действуют на стромальные клетки:
ИЛ-1 ! Стимулируют продукцию ГМ-КСФ, Г-КСФ,
Действуют на стволовые кроветворные клетки:
Фактор стволовых клеток
Действуют на ранние полипотентные кроветворные клетки:
Действуют на клетки, коммитированные по одной или двум линиям:
Примечание: КСФ- колониестимулирующий фактор, Г-гранулоцитарный, М-моноцитарный, ГМ-грануломоноцитарный, ФНО - фактор некроза опухоли.
Краткая характеристика основных ростовых факторов.
1. Интерлейкин-1 (эндогенный пироген, лимфоцит-активирующий фактор).
Имеет две молекулярные формы (ИЛ-1 и ИЛ-1), которые кодируются генами, расположенными на хромосоме 2. Молекулярная масса - 17 килодальтон. Продуцируется большинством клеток организма под воздействием эндотоксина, ГМ-КСФ, -ФНО, ИЛ-2 и ИЛ-1 (аутокринный эффект). Стимулирует выработку других гемопоэтических ростовых факторов (ИЛ-6, ГМ-КСФ, Г-КСФ) опосредованно, путем воздействия на Т-лимфоциты, макрофаги, фибробласты, эндотелиальные клетки.
2. Альфа-фактор некроза опухоли (кахектин).
Молекулярная масса 17 килодальтон. Кодируется геном, расположенным на хромосоме 6. Продуцируется макрофагами, В-лимфоцитами, NK-клетками под влиянием эндотоксина, ГМ-КСФ, ИЛ-3. Как и ИЛ-1, действует опосредованно, стимулируя выработку ростовых факторов (ИЛ-1, Г-КСФ, ГМ-КСФ, ИЛ-6) фибробластами и эндотелиальными клетками. Может выступать также как ингибитор пролиферации клеток-предшественниц.
3. Фактор стволовых клеток (ростовой фактор тучных клеток).
Молекулярная масса 40 килодальтон. Кодируется геном, локализующимся на хромосоме 12. Продуцируется фибробластами, эндотелиальными клетками, стромальными клетками костного мозга. Способствует пролиферации и дифференцировке СКК, а также предшественников тучных клеток
4. Интерлейкин-3 (мультипотентный КСФ).
Молекулярная масса 14 килодальтон. Ген расположен на хромосоме 5. Продуцируется Т-лимфоцитами и тучными клетками при воздействии митогенов. Стимулирует мультипотентные клетки-предшественницы, дифференцировку В-лимфоцитов, индуцирует выработку М-КСФ макрофагами.
5. Интерлейкин-4 (В-клеточный стимулирующий фактор-1).
Молекулярная масса 18 килодальтон. Кодируется геном, который находится на хромосоме 5. Продуцируется Т-лимфоцитами (CD4+ и CD8+). Индуцирует пролиферацию активированных В-лимфоцитов, Т-лимфоцитов и фибробластов, а также экспрессию генов М-КСФ и Г-КСФ моноцитами. Ингибирует высвобождение ИЛ-1 .
6. Интерлейкин-6 (интерферон-2, В-клеточный стимулирующий фактор-2).
Молекулярная масса 26 килодальтон. Ген локализуется на хромосоме 7. Продуцируется макрофагами, эндотелиальными клетками, фибробластами, Т-лимфоцитами в результате индукции ИЛ-1, митогенами и эндотоксином. Стимулирует мегакариоцитопоэз; синергист многих других ростовых факторов (ИЛ-3, М-КСФ, ГМ-КСФ, ИЛ-4).
7. Гранулоцитарно-моноцитарный колониестимулирующий фактор.
Молекулярная масса 18 килодальтон. Ген расположен на хромосоме 5. Продуцируется тучными клетками, Т-лимфоцитами, эндотелиальными клетками, фибробластами после индукции -ФНО, ИЛ-1. Стимулирует рост полипотентных клеток-предшественниц, а также функциональную активность эозинофилов, нейтрофилов, моноцитов и макрофагов.
8. Гранулоцитарный колониестимулирующий фактор.
Молекулярная масса 18 килодальтон. Ген локализуется на хромосоме 17. Продуцируется моноцитами, макрофагами, эндотелиальными клетками и фибробластами в результате индуцирующего воздействия ИЛ-1, -ФНО и эндотоксина. Стимулирует рост коммитированных клеток-предшественниц нейтрофилов, активирует фагоцитарную функцию зрелых нейтрофилов.
9. Моноцитарный колониестимулирующий фактор.
Молекулярная масса 40 килодальтон. Ген расположен на хромосоме 5. Продуцируется моноцитами, макрофагами, фибробластами, эпителиальными клетками, остеобластами и эндотелиальными клетками после индукции ИЛ-3, ИЛ-4 и -ФНО. Индуцирует созревание моноцитов и макрофагов, активирует фагоцитарную и секреторную функцию макрофагов.
10. Интерлейкин-5 (эозинофильный дифференцировочный фактор).
Молекулярная масса 50 килодальтон. Кодируется геном, находящимся на хромосоме 5. Продуцируется Т-лимфоцитами в результате индукции антигенами и митогенами. Стимулирует продукцию и активацию эозинофилов, активирует цитотоксические Т-лимфоциты.
Молекулярная масса 34 килодальтона. Ген расположен на хромосоме 7. Вырабатывается почками в ответ на гипоксию. Стимулирует клональный рост клеток-предшественниц эритропоэза, индуцирует высвобождение ретикулоцитов из костного мозга.
Читайте также:
